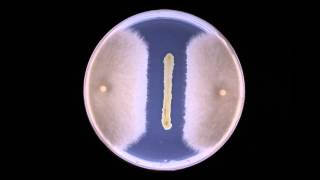

Biocontrol: Fungal inhibition by bacteria Timelapse video
Online izle ve mp4 mp3 formatlarinda yukle
Videonun muddeti: 0:16
Biocontrol: Fungal inhibition by bacteria Timelapse videosu mp4 ve mp3 yuklemek ucun hazirdir
Diqqet! Siz Mp4 yukle ve ya Mp3 yukle duymesine basdiqdan sonra eger sistem sizi reklam sehifesine atarsa o zaman derhal geri qayidib emeliyyati tekrar edin ve faylin yuklemek ucun hazir olmasini gozleyin
Videodan Mp4 Yukle
Videodan Mp3 Yukle-1
Videodan Mp3 Yukle-2
Oxshar Axtarishlar
Biocontrol: Fungal inhibition by bacteria - Timelapse
Washed vs dirty hands bacteria time lapse 🦠🧫 #bacteria #timelapse #shorts
Fungus Growth time lapse #pathology #microbiology #lab_technician #shorts
Fungi and Bacteria Time-Lapse 2 #fungi #bacteria #timelapse
Time lapse: The Growth of Bacteria and Fungi #ambientmusic #fungus #bacteria #timelapse
Fungi Fighting Timelapse
4K Fungi and Bacteria Time-Lapse 11 #fungi #bacteria #timelapse
Fungi and Bacteria Time-Lapse 4 #fungi #bacteria #timelapse
Fungi and Bacteria Time-Lapse 7 #fungi #bacteria #timelapse
Video Mp4 Mp3Azwap.Biz
Azwap.Biz 2021-2023